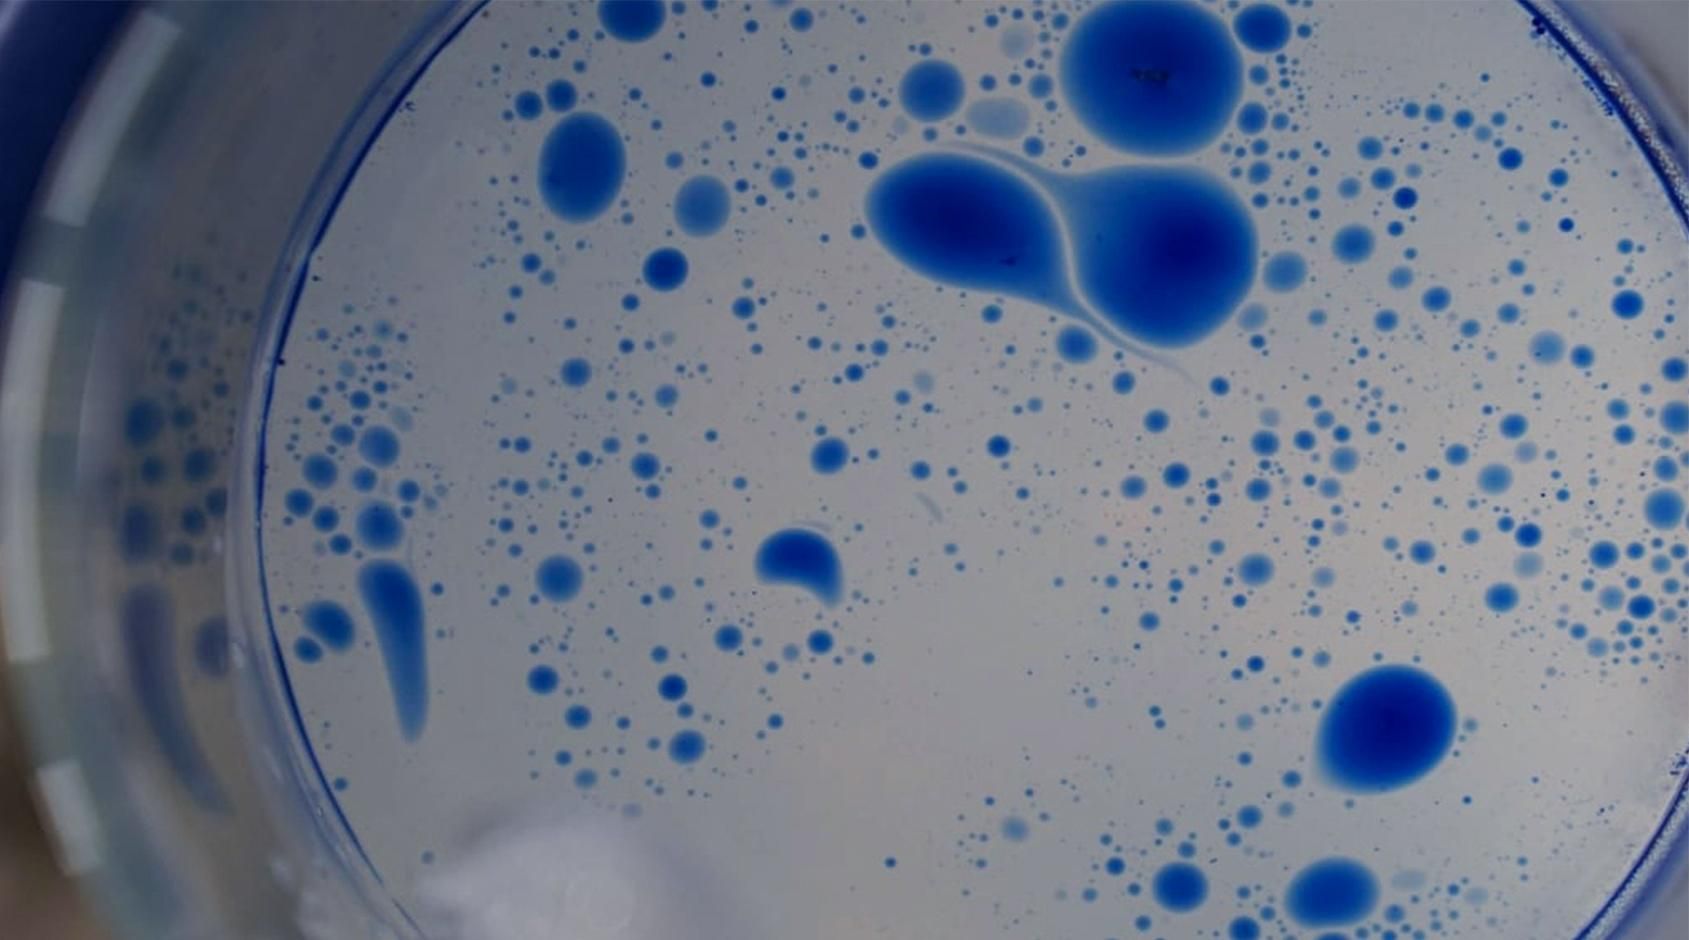

CHAMOMILE BLUE OIL
予定数に達しましたので、今年のご予約は終了させていただきました。
たくさんのご予約誠にありがとうございました。
また来年どうぞよろしくお願いいたします。
<一年の締めくくりに。疲れや緊張を静かにほぐす特別なスキンケアタイムに。>
一年の終わりに向かうこの季節、
使うたび、呼吸が深くなるような「青いオイル」が、今年もできあがりました。
夏に収穫したジャーマンカモミールを蒸留すると、
無色だった液体の中、美しい青があらわれます。
これは “アズレンブルー”。
肌の赤みやゆらぎを静かに落ち着かせると言われてきた、
カモミールならではの成分です。
今年もその貴重な精油を使い、丁寧にオイルへ。
サンダルウッドを重ねた深い香りは、疲れや緊張をやわらげ、
「今日の自分を大切にしよう」と思える時間をつくってくれます。
今年はコットンリネンのポーチ入りです。
ご自身や大切な方へのギフトにも。
<ハーブティーと一緒に>
今年の夏に収穫したジャーマンカモミールをハーブティーにしました。
暑く長かった夏は、カモミールの香りを甘く、強くしてくれました。
紅茶とブレンドしたり、ミルクで煮出して″カモミール・ミルクティー″にして香りを楽しむこともおすすめです。
便利なティーパック入り。ティーパックは生分解性プラスチックを使用しています。
1g×3ヶ入。
甘く豊かに香った夏の名残を、ぜひおたのしみください。
・2025年12月22日前後のお届けとなります。
・価格は 送料込み です。
(レターパックでお届けいたしますので代金引換・お届け日時の指定はできません。)
・クレジットカード払いは、ご注文時に決済が完了します。
・他商品との同梱不可となっております。
・販売予定数に達した場合上記の期間より早く販売を終了させていただくことがございます。
| 全成分 | ●ホホバ種子油、●ゴマ油、スクワラン、コメ胚芽油、ビャクダン種子油、テリハボク種子油、▲カミツレ花油、グレープフルーツ種子油(光毒性フリー)、トコフェロール、大豆種子油 ●はオーガニック認証▲は北海道産原料 |
|---|---|
| 内容量 | 30ml |
| 使用期限 | 開封後3ヶ月 |
| 素材 | 容器・ガラス / キャップ・中栓・ラベル(プラスチック)外箱(紙) |
|---|---|
| サイズ | 高さ4cm × 幅10cm × 奥行き10cm |